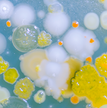
Microbial evolution 220x220.png

Society news
- Order by:
- Date
- A-Z
-
Journal of General Virology Editor-in-Chief: call for expressions of interest
01 July 2025
Journal of General Virology has been publishing peer-reviewed research for more than 50 years. We recognise the importance of virology as a unique discipline within microbiology, and actively collaborates with partners such as the International Committee on Taxonomy of Viruses (ICTV) to support the global virology community.
-
Journal of Medical Microbiology Editor for Molecular and Microbial Epidemiology: Call for expressions of interest
27 May 2025
Journal of Medical Microbiology is the go-to interdisciplinary journal for medical, dental and veterinary microbiology, at the bench and in the clinic. It provides comprehensive coverage of medical, dental and veterinary microbiology and infectious diseases, welcoming articles ranging from laboratory research to clinical trials, including bacteriology, virology, mycology and parasitology.
- Order by:
- Date
- A-Z
-
Abstracts Submissions now opened for Blastocystis 2023
30 January 2024
We are pleased to announce a call for public abstracts for Blastocystis 2024, taking place 18–19 September 2024, in Greece in the vibrant city of Crete.
Submissions are now open and will close on 30 April 2024 at 23:59 BST.
-
Access Microbiology Editor and Editor Mentee roles: call for expressions of interest
19 November 2024
Access Microbiology is an open research platform that encourages the publication of replication studies, negative or null results, research proposals, data management plans, additions to established methods, case reports, genome announcements and interdisciplinary work. It covers the full spectrum of microscopic life forms, from bacteria and viruses to fungi, protists, archaea, and algae. The platform welcomes all approaches, from computational, biotechnology, and laboratory work, to environmental, clinical, and veterinary studies. It also publishes pedagogy papers on microbiology education.
-
Journal of General Virology Editors and Board of Reviewers: call for expressions of interest
17 October 2024
Journal of General Virology has been publishing peer-reviewed research for more than 50 years. We recognise the importance of virology as a unique discipline within microbiology, and actively collaborate with partners such as the International Committee on Taxonomy of Viruses (ICTV) to support the global virology community.
-
Journal of Medical Microbiology Senior Editor for Antimicrobial Resistance: Call for expressions of interest
06 September 2024
The Journal of Medical Microbiology (JMM) is an interdisciplinary journal for medical, dental and veterinary microbiology, at the bench and in the clinic. It provides comprehensive coverage of medical, dental and veterinary microbiology and infectious diseases, welcoming articles ranging from laboratory research to clinical trials, including bacteriology, virology, mycology and parasitology.
-
Microbial Genomics Senior Editor and Editors: call for expressions of interest
20 November 2024
Microbial Genomics is the open access journal of choice for genome research spanning the breadth of microbial life including viruses, bacteria, archaea and microbial eukaryotes. We welcome articles showing novel insights, new applications, or innovative approaches using genomic data. Content ranges from comparative and functional genomics of model organisms to population-scale evolution, epidemiology and microbiome studies, and real-world genomics applications with clinical, veterinary or environmental relevance.
- Order by:
- Date
- A-Z
-
Young Microbiologist of the Year 2023 Competition Finalists
31 July 2023
The Microbiology Society is pleased to announce the finalists of the 2023 Sir Howard Dalton Young Microbiologist of the Year competition.
-
Abstract submission for Annual Conference 2024 is now open
11 October 2023
The Microbiology Society is pleased to announce that abstract submission for Annual Conference 2024 is now open.
Annual Conference 2024 will take place on Monday 8 April–Thursday 11 April 2024 at Edinburgh International Convention Centre. We welcome everyone from across our community to join us in Edinburgh in 2024. The four days will consistof scientific symposia, workshops, fora, professional development sessions, Prize Lectures, and much more.
-
Abstract submissions close in on week for Candida and Candidiasis 2023
10 February 2023
Abstract submissions close in one week on Friday 17 February 2023 (23:59 GMT) for Candida and Candidiasis 2023, taking place 13–17 May 2023 in Montréal, Canada for the first time.
-
Abstract submissions now open for anaerobe 2023
20 March 2023
We are pleased to announce a call for public abstracts for Anaerobe 2023, taking place 12–14 July 2023, at the Leonardo Hotel Cardiff.
-
Access Microbiology Editor: Call for expressions of interest
10 July 2023
Access Microbiology is the Microbiology Society’s open research platform - publishing replication studies, negative results, case reports, research proposals, data management plans, additions to established methods, and interdisciplinary work. It covers the full spectrum of microscopic life forms and welcomes all approaches, from computational, biotechnology, and laboratory work, to environmental, clinical, and veterinary studies. It also publishes pedagogy papers on microbiology education.
- Order by:
- Date
- A-Z
-
Journal of Medical Microbiology Deputy Editor-in-Chief: Call for expressions of interest
01 February 2022
Journal of Medical Microbiology is the go-to interdisciplinary journal for medical, dental and veterinary microbiology, at the bench and in the clinic. It provides comprehensive coverage of medical, dental and veterinary microbiology and infectious diseases, welcoming articles ranging from laboratory research to clinical trials, including bacteriology, virology, mycology and parasitology.
-
A new front in microbial warfare – researchers explore a bacterial nano-weapon that targets pathogenic yeasts
07 September 2022
When it comes to disease-causing microbes, bacteria and viruses usually steal the spotlight. But there is another, often overlooked, microbial foe that is a grave cause for concern. Fungal pathogens cause an estimated 1.5 million human deaths and destroy a third of the global crop yield each year. Despite this impact on human health and food security, the number of antifungal drugs available is extremely limited.
-
A statement from Council
23 March 2022
In common with the majority of the world, the Council of the Microbiology Society deplores the senseless violence, suffering and death caused by Russia's invasion of Ukraine. We reiterate our statement of 9 March that science is universal and we are continuing to try to contact our members in Ukraine to offer our support. We again underline our willingness to help our Ukrainian colleagues and partners wherever practical ways can be found, including by supporting at-risk academics via CARA, and by ensuring that Ukrainian scientists have unrestricted access to our published content via the Research4Life initiative.
-
Abstract submission and registration for Annual Conference 2023 are now open
24 October 2022
The Microbiology Society is pleased to announce that abstract submission and registration for Annual Conference 2023 are now open
-
Abstract submission closes in one week for Understanding and Predicting Microbial Evolutionary Dynamics
23 August 2022
Abstract submission closes on Tuesday 30 August 23:59 BST for Understanding and Predicting Microbial Evolutionary Dynamics. The Focused Meeting will take place 22–23 November 2022 at Hyatt Regency Manchester, UK.
- Order by:
- Date
- A-Z
-
Journal of General Virology Editors: call for expressions of interest
01 November 2021
We’re looking for new Editors to join the Journal of General Virology. Editors of Journal of General Virology play a key role in the journal, ensuring that we publish high-quality research, and are engaged with the virological community.
-
Journal of Medical Microbiology and Journal of General Virology to award prizes for presentations at Avian Infectious Diseases 2021
08 February 2021
The Journal of Medical Microbiology and Journal of General Virology are delighted to announce that two prizes will be awarded during the Avian Infectious Diseases 2021 Focused Meeting taking place on 15–17 September 2021.
-
Journal of Medical Microbiology to award ‘Most Promising Science Prize’ at Anaerobe 2021
03 June 2021
The Journal of Medical Microbiology is delighted to announce that it will be awarding a prize at the Anaerobe 2021 Focused Meeting taking place digitally from 15–16 July 2021.
-
Microbial Genomics welcomes functional genomics submissions
10 March 2021
Microbial Genomics is a Gold Open Access, peer-reviewed journal publishing cutting edge genome research spanning the breadth of microbial life. Since the journal’s launch in 2015, the field of microbial genomics has continued to evolve.
-
Microbiology Editors: Call for expressions of interest
08 November 2021
Microbiology brings together communities of scientists from all microbiological disciplines and from around the world, and we are looking for new Editors to join the Editorial Board.
- Order by:
- Date
- A-Z
-
2020 events postponement
16 March 2020
Following the decision taken to cancel our Annual Conference and postpone our Candida Focused Meeting, the Council of the Microbiology Society, as Trustees of the Society, have taken the difficult decision to postpone all events in our programme for the remainder of 2020, due to the continued spread of SARS-CoV-2, the cause of COVID-19.
-
75th anniversary: A visual showcase of your Microbiology Image submissions
21 April 2020
Since launching the Microbiology Images project last year, we have received over 100 image submissions which fell under the categories of science, nature, people, places and the laboratory.
-
75th anniversary: Microbiology Book Club
05 March 2020
Today, to coincide with World Book Day 2020, we are launching a new activity to celebrate microbiology in literature as part of our 75th anniversary activities. This project is inspired by Honorary member, Professor Joanna Verran, who runs the Bad Bugs Book Club.
-
Microbiology Reviews Editor: Call for expressions of interest
29 April 2020
As the founding and flagship journal of the Microbiology Society, Microbiology brings together communities of scientists from all microbiological disciplines and from around the world. Originally named Journal of General Microbiology, we have been publishing the latest advances in microbiology since 1947. Today the journal reflects the diversity and importance of microbiology in addressing current global challenges, such as food security, environmental sustainability, and health, by publishing fundamental and applied research across the breadth of the field.
-
A Sustainable Future policy reports published today
17 December 2020
Today, the Microbiology Society has published three reports on the opportunities and challenges microbiology faces in areas of key sustainability.
To mark the 75th anniversary of the Microbiology Society, we embarked on an ambitious project that demonstrates the value and raises the profile of microbiology in addressing the world’s biggest challenges.
- Order by:
- Date
- A-Z
-
A Sustainable Future: the role of microbiology in achieving the UN Sustainable Development Goals
25 January 2019
To celebrate the Microbiology Society’s 75th anniversary in 2020, we are launching a wide-ranging programme of events and activities to showcase why microbiology matters and demonstrate the impact of microbiologists past, present and future in addressing global challenges.
-
10 June 2019 - Event proposal applications and Society-Supported Conference Grants deadline
13 May 2019
Organising an event? The Microbiology Society can provide full secretariat support services or financial support to members depending on the type of event being organised.
-
2020 and 2021 Focused Meeting proposals deadline
03 October 2019
The deadline for 2020 and 2021 Focused Meeting proposals is on Friday 11 October. Submit your proposal for an event focusing on microbiology.
-
75th anniversary of the Microbiology Society: get involved
10 April 2019
To celebrate our 75th anniversary in 2020, we are launching a wide-ranging programme of events and activities to showcase why microbiology matters and to demonstrate the impact of microbiologists past, present and future.
-
75th anniversary: Microbiology Images
25 March 2019
As part of the celebrations for our anniversary, we invite the microbiology community to submit images related to the microbiological world to help highlight how microbiology answers big questions by giving us knowledge of very small things. We welcome images of your science, of nature, of people, places and events that will inspire, inform and demonstrate how the study of microbes helps us to understand our world and our place within it.
- Order by:
- Date
- A-Z
-
75th anniversary of the Microbiology Society: celebrating the impact of microbiologists past, present and future
29 November 2018
To celebrate our 75th anniversary in 2020, we are launching a wide-ranging programme of events and activities to showcase why microbiology matters and demonstrate the impact of microbiologists past, present and future.
-
Bacterial World opening at Oxford University Museum of Natural History
19 October 2018
A new exhibition called Bacterial World that is opening at the Oxford University Museum of Natural History on 19 October is seeking to rehabilitate the reputation of bacteria and counter the popular misconception that they are all bad, or to be feared.
-
A big thank you to all our members and volunteers
07 June 2018
Most of our members are very aware of the opportunities that come with being a part of the Society: the grants we make available, the conferences and events we run, as well as the growing professional development programme and the networks that open up through membership.
-
Abstract submission deadline for 2018 Focused Meeting on the Molecular Biology and Pathogenesis of Avian Viruses
18 June 2018
The abstract submission deadline for the Focused Meeting on the Molecular Biology and Pathogenesis of Avian Viruses is Sunday 24 June.
-
Abstract submission deadline for Emerging Zoonoses and AMR Focused Meeting
29 May 2018
The abstract submission deadline for the Emerging Zoonoses and AMR Focused Meeting is Sunday 3 June.
- Order by:
- Date
- A-Z
-
A week left to submit your Annual Conference 2018 abstract
04 December 2017
The Microbiology Society’s Annual Conference is the largest gathering of microbiologists in the UK. Next year’s event will take place from Tuesday 10 April to Friday 13 April at the ICC Birmingham – with the abstract submission deadline fast approaching, don’t miss out on your chance to present.
-
An unbalanced microbiome on the face may be key to acne development
06 April 2017
Today at the Microbiology Society’s Annual Conference, researchers will show that the overall balance of the bacteria on a person’s skin, rather than the presence or absence of a particular bacterial strain, appears to be an important factor for acne development and skin health.
-
Annual Conference 2017 Poster Prizes
22 March 2017
Over 600 delegates have been selected by the Society’s Divisions to present their posters at this year's Annual Conference, making this our biggest poster exhibition yet. The posters provide an excellent way to showcase scientific research related to sessions going on each day.
-
Annual Conference 2017 – poster prize winners
27 April 2017
This year’s Annual Conference saw the biggest poster exhibition yet, with over 600 abstracts selected by the Society’s Divisions. The posters provided an excellent opportunity for microbiologists to showcase scientific research that complemented sessions running each day. This year the Microbiology Society introduced a number of poster prizes to recognise delegates who demonstrated excellent presentation skills or highlighted novel research.
-
Annual Conference 2017: fewer than 50 days away
13 February 2017
We are halfway through February and there are now fewer than 50 days to go until the start of the Microbiology Society Annual Conference 2017, taking place 3–6 April in Edinburgh.
- Order by:
- Date
- A-Z
-
Journal of Medical Microbiology is looking for a new Editor-in-Chief
25 May 2016
The Microbiology Society’s Journal of Medical Microbiology is looking for a new Editor-in-Chief and is seeking expressions of interest from experts in the field.
-
Microbial Genomics collaborates with Microreact, an epidemic tracking platform
30 November 2016
The Microbiology Society is pleased to announce a new collaboration between Microbial Genomics and Microreact, a free data visualisation and sharing platform that allows scientists and health professionals worldwide to better collaborate to understand disease outbreaks.
-
Abstract submissions open for 2016 Focused Meetings
19 January 2016
Abstract submission for the Society’s 2016 Focused Meetings is now open. This year, we will host two meetings: Molecular Biology of Archaea 5 (1–3 August) and Molecular Biology and Pathogenesis of Avian Viruses (27–29 September), which will be held at the London School of Hygiene and Tropical Medicine, and Charles Darwin House, London, respectively.
-
All United Nations countries to sign declaration to fight antimicrobial resistance
22 September 2016
The Microbiology Society is delighted that all 193 countries of the United Nations have agreed to sign a landmark declaration to fight the growing threat of antimicrobial resistance (AMR) at the UN High Level Meeting on Antimicrobial Resistance.
-
Announcing a new collaboration between Journal of General Virology and the International Committee on Taxonomy of Viruses (ICTV)
18 October 2016
From January 2017, Journal of General Virology will publish ICTV Virus Taxonomy Profiles – a new series of concise review-type articles that summarise the individual chapters from the ICTV’s online (10th) Report on Virus Taxonomy.
- Order by:
- Date
- A-Z
-
2015 UK Budget commits funds to combat antimicrobial resistance
18 March 2015
Today, the UK Chancellor George Osborne MP announced the Government’s budget for 2015. While not announced during the Chancellor’s traditional speech, there was mention of antimicrobial resistance in the full budget statement, which contains information not mentioned in the speech.
The report describes how the Government is to work with various organisations to create the ‘Fleming Fund’, aimed at building capacity in low- and middle-income countries.
-
70th Anniversary Collection for the Microbiology Society
15 December 2015
2015 marked the 70th anniversary of the Society, which was formally inaugurated on 16 February 1945 at a meeting at the London School of Hygiene and Tropical Medicine, when Sir Alexander Fleming was elected as President.
-
Abstract submission open for Society Focused Meetings
22 April 2015
In September, the Society for General Microbiology is hosting two Focused Meetings: The International Meeting on Arboviruses and their Vectors and The International Meeting on The Invasive Fungus. Abstract submission for both events is now open.
-
Animal research jeopardised by European Citizens’ Initiative
08 May 2015
On Monday 11 May, a public hearing in the European Parliament will see organisers of the Stop Vivisection European Citizens’ Initiative (ECI) call for European Directive 2010/63/EU, which regulates the welfare and use of animals in research, to be repealed and replaced with legislation to end animal experimentation.
Over 1.1 million people, including more than 19,000 from the UK, signed the Stop Vivisection ECI petition, which argues for EU legislation changes to ban animal experimentation on the grounds of ethical objections and “solid scientific principles that invalidate the ‘animal model’ for predicting human response”.
-
Annual Conference 2016 invited speaker: Dr Kirsten Benjamin
09 December 2015
From 21–24 March, the Microbiology Society will be holding its 2016 Annual Conference at the Arena and Convention Centre (ACC), Liverpool, UK. The meeting will be attended by over 1,000 delegates from across the world, and will feature presentations from a wide range of microbiology-related disciplines.
- Order by:
- Date
- A-Z
-
2013 impact factors announced for Society journals
05 August 2014
The 2013 journal impact factors have now been released and overall it is positive news for the journals at the Society for General Microbiology.
The impact factor of an academic journal is defined by Thompson Reuters and measures citations to evaluate its importance within its field of study. -
2014 Society Prize Winners announced
03 March 2014
Congratulations go to the microbiologists who have been awarded this year's Society Prizes. They include Professors Rita Colwell, Nikolay Zenkin, Laura Piddock and Stephen Curry.
-
Avian flu - the facts
16 December 2014
In recent weeks there has been a number of news reports covering an outbreak of H5N8 avian flu (also known as bird flu), which has lead to the mass culling of poultry at farms in Germany, the Netherlands and the UK. The World Health Organization has also been notified of three new human cases of a different avian flu strain found in China, H7N9, one of which has been fatal. But what is avian flu? Is it something we should be worried about? To find out more, we spoke to Wendy Barclay, Professor of Influenza Virology at Imperial College London.
-
British Government reviews its Antimicrobial Resistance Strategy
11 December 2014
In September 2013, the British Government published the UK Five Year Antimicrobial Resistance Strategy 2013 to 2018, which detailed proposals to slow the development of antimicrobial resistance (AMR).
-
Call for Application: Partner wanted for match-funded PhD studentship
08 December 2014
The Society for General Microbiology is looking for a university or institution to collaborate on a cross-disciplinary match-funded PhD studentship, as part of our work with the Small World Initiative.
- Order by:
- Date
- A-Z
-
2014 journal pricing is now available
21 June 2013
2014 subscription prices for Microbiology, Journal of General Virology, Journal of Medical Microbiology and International Journal of Systematic and Evolutionary Microbiology are now available.
-
Antibiotic 'apocalypse' warning
24 January 2013
The rise in drug resistant infections is comparable to the threat of global warming, according to the chief medical officer for England.
-
Antibiotic resistance 'a catastrophic threat'
11 March 2013
The Government's Chief Medical Officer, Professor Dame Sally Davies, states that a growing resistance to antibiotics should be ranked along with terrorism on a list of threats to the nation. Nigel Brown, President of the Society for General Microbiology, backed Dame Sally's comments stating that urgent action is required by microbiologists and other scientists to identify and produce new antibiotics, and to tackle the problem of antibiotic resistance and its transmission
-
Come and help us give bacteria the brush off!
18 February 2013
-
Early HIV drugs 'slow virus down'
15 January 2013
Giving a patient HIV drugs as soon as they are diagnosed could be the future of treatment, say researchers. Currently, antiretroviral therapy is given only once the immune system has been seriously weakened by infection. A trial, in the New England Journal of Medicine, showed that a year-long course of therapy after diagnosis helped preserve the immune system and keep the virus in check. (BBC)
- Order by:
- Date
- A-Z
-
Coconut oil could combat tooth decay
03 September 2012
Digested coconut oil is able to attack the bacteria that cause tooth decay. It is a natural antibiotic that could be incorporated into commercial dental care products, say scientists presenting their work at the Society for General Microbiology’s Autumn Conference at the University of Warwick.